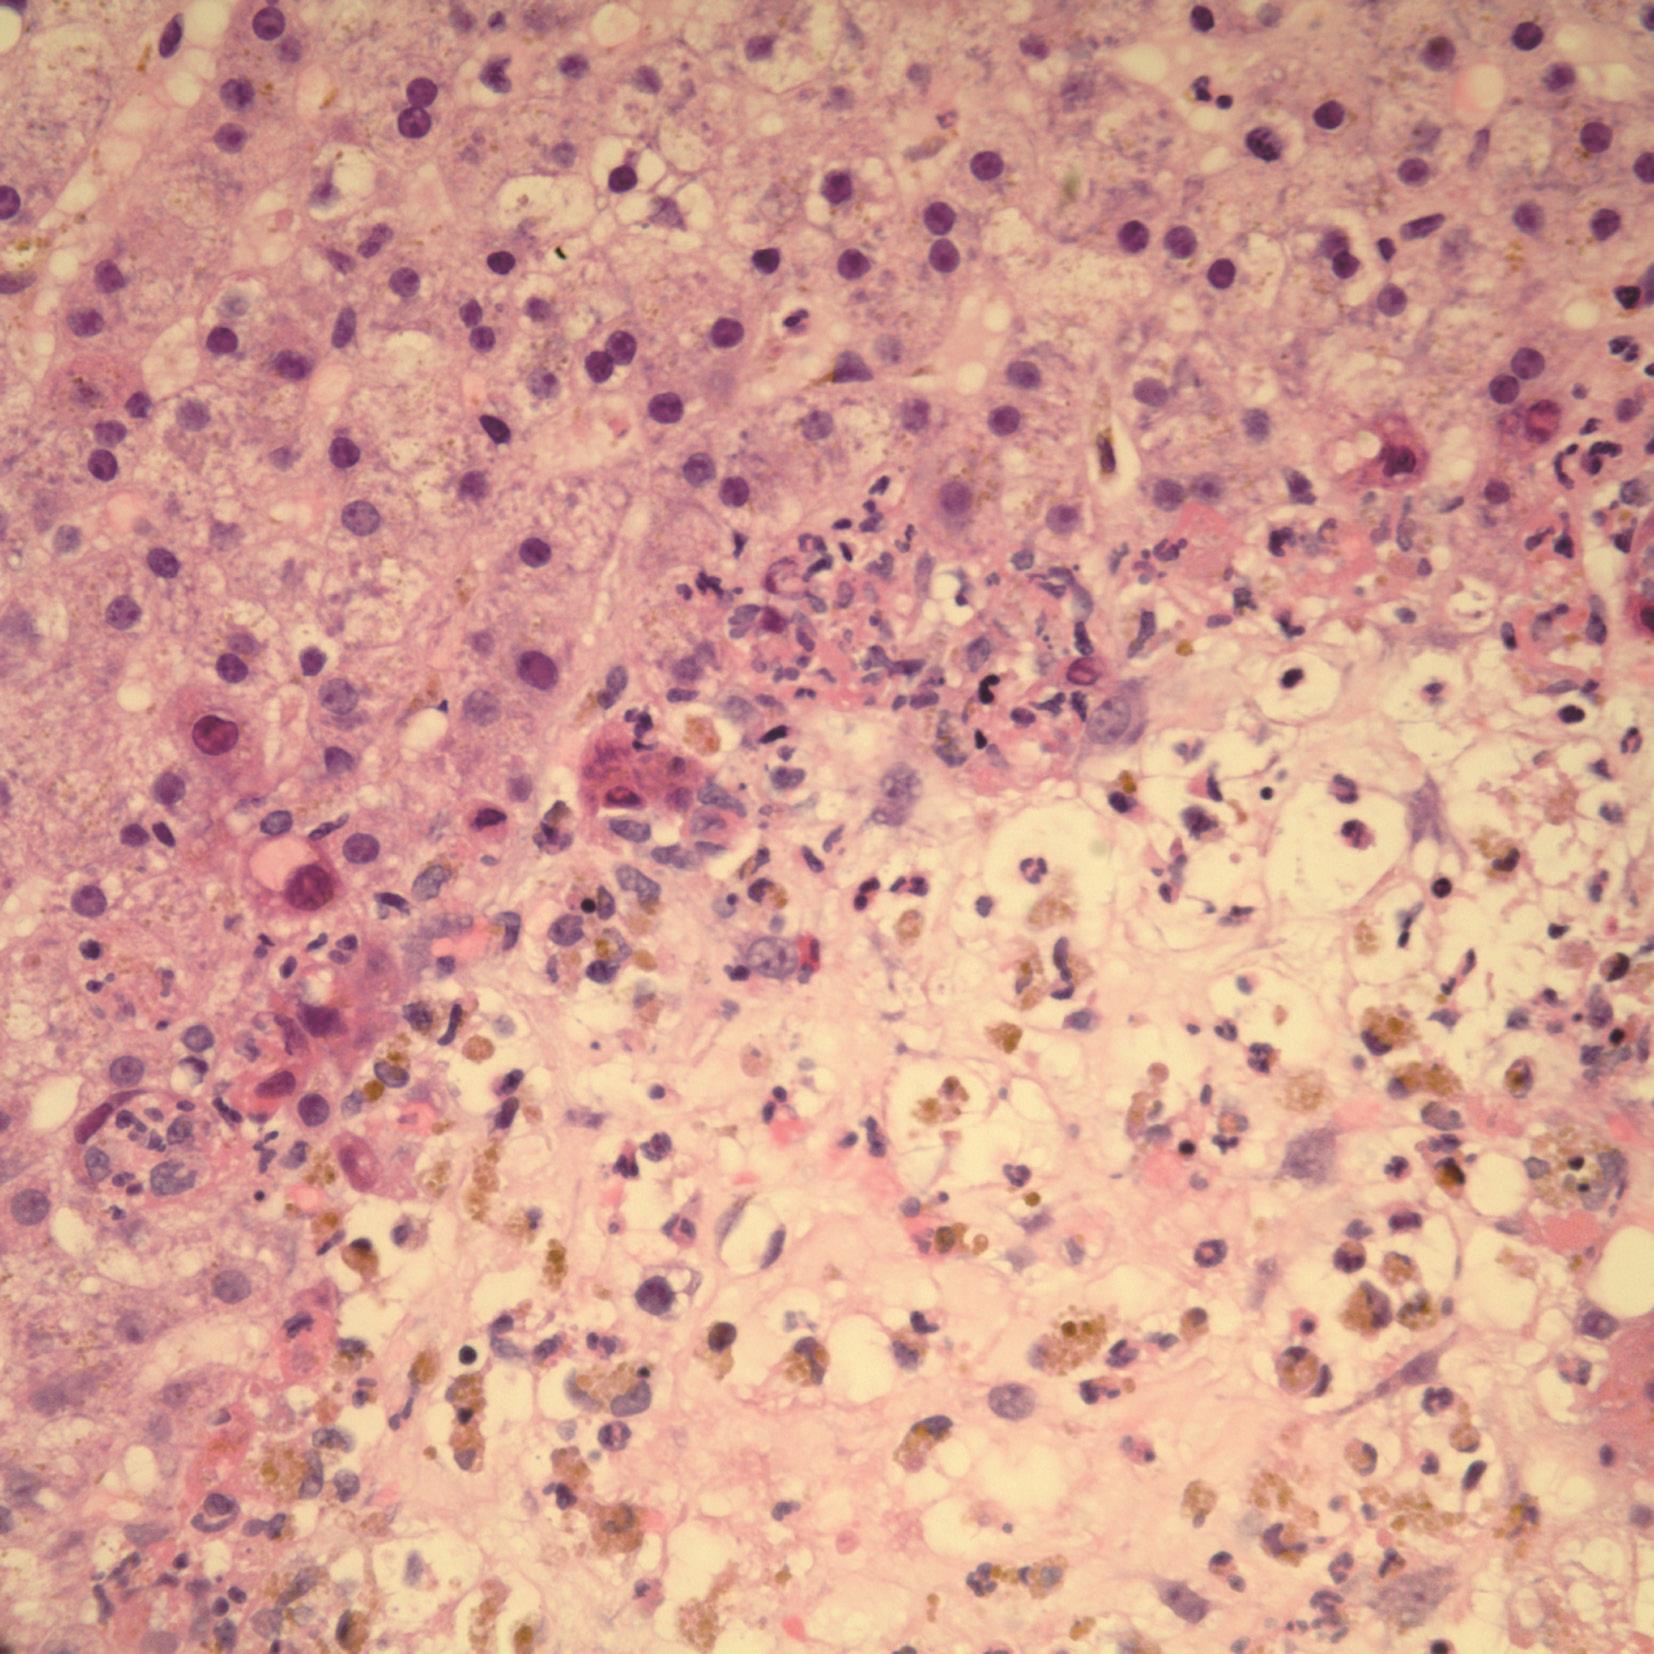

传统理论认为,急性病毒性肝炎的病理组织学特征是肝细胞发生点状或灶状坏死,这是经典的急性病毒性肝炎。近年来发现,在一些急性病毒性肝炎病例,也可见到稍大范围的坏死,在组织中有时可见桥接坏死、肝腺泡坏死或门管区旁坏死。因而按照肝组织病变范围的大小、病变的部位以及组织、细胞病变的特点,在病理形态学上可将急性病毒性肝炎分为经典的急性病毒性肝炎、伴有桥接坏死的急性病毒性肝炎、伴有全肝腺泡或多肝腺泡坏死的急性病毒性肝炎以及伴有门管区旁坏死的急性病毒性肝炎。这些构成了急性病毒性肝炎的主要病理组织形态学特征。近年来,随着检测各型肝炎病毒方法的成熟,发现不同肝炎病毒引起的急性病毒性肝炎,其组织学改变既有其共性,又有其个性。因而在分类上,提倡应用结合病毒病因的病理组织学分类。
急性病毒性肝炎可以散发或流行,主要传播途径包括粪-口传播、血液传播、性接触、母婴途径传播。急性肝炎患者常无症状和体征,部分常表现为无特异性改变。病毒性肝炎的特异性改变早期包括乏力、厌食和恶心,随后出现尿色加深和黄疸,右上腹疼痛或不适,荨麻疹、瘙痒或低热。没有黄疸症状的患者易误诊为胃肠道病毒感染或其他非特异性病毒感染综合征。严重的急性肝炎可出现致命性的肝衰竭。急性肝炎以肝细胞损伤为主要特征,因此肝功能检查时患者的氨基转移酶显著增高,并且常先于胆红素出现。同时,肝脏合成凝血因子水平下降,常使凝血时间延长,iNOS水平升高,这是急性肝损伤的另一个表现。转氨酶水平升高常持续数周,部分患者由于病毒被清除转氨酶可以在数周或数月后恢复正常。淤胆性肝炎是急性病毒性肝炎的一种临床亚型,以胆道系统功能异常为主要表现。此型主要表现为碱性磷酸酶和胆红素水平升高,淤胆有关的生物学指标异常常持续数周或数月。此型肝炎预后优于伴有显著肝细胞坏死的急性肝炎。同时淤胆性肝炎需要与胆道系统梗阻鉴别。
经典的急性病毒性肝炎的病理组织学改变是肝细胞损伤,并见淋巴细胞、巨噬细胞等炎症细胞浸润。肝细胞的损伤包括肝细胞变性和坏死。变性主要有三种形式,肝细胞气球样变、嗜酸性变及脂肪变性。显微镜下可见气球样变的肝细胞体积增大、肿胀、变圆,胞质见颗粒状淡染,甚至空泡状,形似气球。嗜酸性变的肝细胞形状不规则,胞质强嗜酸性,染成深伊红色,可能是凋亡小体的前身,又称为嗜酸小体或Councilman小体,这些小体是从肝板上脱落下的体积缩小的肝细胞或其一部分。凋亡小体常为圆形,可含有或不含有固缩的核。虽然在急性病毒性肝炎时可见到大量典型的凋亡小体,但这些凋亡小体并不是急性病毒性肝炎的诊断特征。因为在其他的肝损伤,甚至在正常肝组织中也可见到凋亡小体。部分急性病毒性肝炎可见肝细胞脂肪变性。脂肪变性的肝细胞体积增大、肿胀、变圆,胞质内可见大小不等的脂肪空泡。刚发生脂肪变性时,肝细胞内的脂肪空泡较小,多位于细胞核的周围,以后逐渐变大,较密集地散布于整个胞质中,严重时可融合成一大空泡,将细胞核挤向细胞一侧的胞膜下,状似脂肪细胞。曾有学者认为,凡在组织学水平查见肝细胞中有脂肪空泡,都视为肝炎慢性化的表现。因为大量的急性肝炎活检中,很少见有脂肪空泡。但近年来丙型肝炎肝活检病理组织学检查日益增多,在其急性期也可以观察到肝细胞的脂肪变性,并视为与甲型及乙型肝炎的鉴别要点之一。结合肝细胞气球样变、嗜酸性变、凋亡小体形成、其他肝细胞增生变大、肝细胞失去正常排列结构,有助于对急性病毒性肝炎的诊断。
上述改变可见于整个肝腺泡,但在靠近中央静脉盲端的Ⅲ区损伤最严重。主要发生在Ⅰ区的损伤则较少见,但有时这是甲型病毒性肝炎的特征。Ⅲ区内肝细胞损伤的程度也不同,有的细胞损伤严重,表现为点状或灶状坏死。有些更严重的病例,坏死可更严重。肝血窦塌陷,导致在一些急性病毒性肝炎中所见的门管区扩大。
在急性病毒性肝炎肝中常见胆汁淤积,这是由于肝细胞胆汁分泌及输送功能障碍引起的,有时是由于门管区胆道中胆汁流动障碍引起。胆小管管腔内可见胆栓,但胆管腔不像胆道阻塞时扩张得那么明显。胆汁淤积性肝炎是指临床上持续较长时间胆汁淤积的肝炎,这些患者组织切片上见明显的胆汁淤积,且在其他损伤恢复后,仍见胆汁淤积。
除了肝细胞不同类型的损伤外,还可见肝腺泡炎症细胞浸润,主要是活化的T淋巴细胞,淋巴细胞增多可能是由于肝窦内皮细胞上黏附因子表达增多所致。早期也可见浆细胞浸润。Kupffer细胞变大,特别是在肝腺泡的Ⅲ区,胞质中有棕色、富含脂汁的色素颗粒。
虽然肝实质的损伤是病毒性肝炎最重要的组织学特征,但大多也累及门管区。门管区可见炎症细胞浸润,与肝腺泡炎症细胞浸润一样,主要是淋巴细胞和浆细胞,也常见中性粒细胞、嗜酸性粒细胞和巨噬细胞。炎症细胞浸润常超出门管区的范围,累及邻近的肝实质,可能会与慢性肝炎的碎屑状坏死混淆。门管区旁肝细胞发生凋亡以及炎症细胞浸润区见肝细胞,提示为慢性改变,但通常不易区别,需要将肝腺泡的改变及临床资料加以综合分析。
胆管及胆小管的增生通常不是急性病毒性肝炎的主要特征,除非伴有脓毒血症或非常严重的肝细胞坏死。后者在门管区见胆管及胆小管的增生,似胆管阻塞的改变。但结合整个组织学特点,可作出正确的诊断。在急性病毒性肝炎,特别是丙型病毒性肝炎,常见小叶间胆管上皮损伤,损伤的胆管常在淋巴滤泡浸润的中央或周围。胆管上皮细胞呈灶性复层、形态学改变并呈空泡化。临床资料有助于与原发性胆汁性胆管炎鉴别诊断。肉芽肿的形成并非病毒性肝炎胆管损伤的特征。
有些急性病毒性肝炎,肝细胞坏死广泛,以致坏死区桥状连接门管区和中央静脉,称为桥接坏死。这种坏死形式代表了整个肝腺泡Ⅲ区的融合坏死。这些坏死桥也称为中央静脉-门管区桥,不同于门管区-门管区桥,后者主要是由于门管区旁坏死和门管区增宽引起。因而桥接肝坏死在这里仅限于指中央静脉-门管区坏死,任何类型的肝炎病毒都可能引起这种坏死。桥接肝坏死表明发生严重的肝炎,这些患者比仅有点状坏死的急性病毒性肝炎更易于在发病后数周内死亡,或发展为慢性肝炎。但如果损伤处充分再生,桥接肝坏死可完全恢复。
坏死桥包括塌陷的结缔组织网,其间有巨噬细胞、其他炎症细胞及血管。坏死桥通常呈弧形,可能反映了肝腺泡Ⅲ区的形态。它们可被误认为慢性肝炎的纤维带,可通过弹力纤维染色加以区别,因为新形成的坏死桥为阴性反应,而形成较久的坏死桥,纤维带为阳性反应。较大量的弹力纤维组织需数月方可形成,但少量的弹力纤维可早在肝炎发病后1~2个月以敏感的维多利亚蓝染色检测出。
在少数患者,融合坏死可扩展至整个肝腺泡(全肝腺泡坏死)或几个相邻的肝腺泡(多肝腺泡坏死)。这一类型特别常见于临床暴发性、产生肝性脑病的肝炎,也可见于较不严重感染的患者,坏死可迅速发展到肝包膜。有时在慢性肝炎肝包膜下可见到类似的病变。在显微镜下,全肝腺泡坏死的肝实质被塌陷的间质、炎症细胞及巨噬细胞取代。在门管区内及其周围,可见增生的管样结构。组成这些结构的部分细胞有内分泌特征,可能代表了一群干细胞向肝细胞分化。这些细胞被认为在肝细胞再生不足时,可开始它的再生活动。极少数的全肝腺泡坏死病例,门管区的改变可似胆管阻塞的特征。
虽然大多数的急性病毒性肝炎坏死和炎症最严重的是在肝腺泡Ⅲ区,但一些患者也可主要表现为门管区和门管区旁损伤。门管区炎症细胞浸润和门管区旁肝细胞损伤也可与上述各种病变伴发。门管区旁肝细胞损伤与慢性肝炎的碎屑状坏死很相似,可误诊,但急性病毒性肝炎伴门管区旁肝细胞坏死有可能完全恢复。在急性甲型肝炎或戊型肝炎时,有时也可见到此种病变。除临床流行病学及甲型肝炎病毒或戊型肝炎病毒标志物的检测可作为诊断的重要参考条件外,组织学变化的某些形态也可作为鉴别诊断的依据。一般认为甲型肝炎或戊型肝炎时常见淋巴细胞及浆细胞挤入肝小叶的周边区,甚至出现肝细胞的脱落,出现类似于轻型慢性活动性肝炎的表现,但不会导致慢性肝炎。因此在做肝穿刺病理诊断肝炎时,强调需结合临床和血清学的检查。
甲、乙、丙、丁、戊、庚等型急性病毒型肝炎的病理变化大部分相似,急性病毒性肝炎的病原分型不能单纯依靠组织学形态确诊,但各型肝炎之间有些不同的特性。组织学形态可能会因为存在两种病毒感染或因酒精等引起另外的肝损伤而混淆。
在不严重的甲型肝炎病毒感染引起的急性甲型病毒性肝炎,很少进行肝穿刺检查。做肝穿刺检查可能是为了明确是否同时存在其他肝脏疾病,或用于判断急性肝衰竭患者肝细胞坏死的程度。急性甲型病毒性肝炎的组织学改变主要表现为散在的肝小叶炎症,肝细胞肿胀,呈气球样变或嗜酸性变,部分肝细胞形成嗜酸性小体,肝细胞肿胀使肝窦狭窄;可见肝细胞点状坏死,典型的点状坏死和伴发的再生使肝板排列紊乱;Kupffer细胞增生,细胞体积增大;伴有门管区及门管区旁单个核细胞的浸润。虽然甲型肝炎病毒感染常有门管区旁(肝腺泡Ⅰ区)炎症和坏死,但肝小叶内的病变在中央静脉旁(肝腺泡Ⅲ区)更明显。
急性甲型病毒性肝炎有两种组织学特征,可分别或共同存在。第一种病变特点如上所述,门管区旁坏死及大量炎症细胞浸润门管区,浸润的细胞主要是淋巴细胞和巨噬细胞,也包括中性粒细胞、嗜酸性粒细胞及浆细胞,门管区由于炎症浸润和伴发的水肿而扩大,易被误诊为慢性肝炎。另一种病变特点为中央静脉旁胆汁淤积,胆汁淤积性肝炎可见胆小管内胆栓形成,而肝细胞变性轻微,多呈小的点状、灶状坏死,易被误诊为阻塞性肝病。以上两种病变是有关联的,胆汁淤积可由于门管区旁坏死导致胆流阻断而引起。也可见其他的肝脏炎症改变,部分患者表现为经典的病毒性肝炎即肝细胞气球样变、溶解性坏死等。可发生融合性坏死,指较大范围的坏死,坏死在肝腺泡内扩展,常发生门管区和中央静脉之间的桥接坏死。更广泛的坏死为亚大块或大块坏死,肝小叶网状支架塌陷,这些坏死常有急性肝衰竭的临床症状,但伴有多肝腺泡坏死的急性重型肝炎很少见。
电镜下可见肿胀的肝细胞电子密度高于正常肝细胞,细胞内滑面内质网增多,大部分肝细胞内胆汁淤积,可见50~300nm深浅不等的小圆颗粒,分布在近胆小管周的胞质中。常在丁型病毒性肝炎中所见的广泛肝细胞微囊状改变,也可见于严重的急性甲型病毒性肝炎。
免疫组化染色显示肝细胞内有病毒抗原;病毒RNA可用原位杂交法在组织切片中检测出。对甲型病毒肝炎的病理诊断主要通过免疫组化检测出甲型肝炎病毒抗原、免疫电镜下观察到HAV颗粒,或原位杂交检测出甲型肝炎病毒RNA,再结合甲型肝炎的相对组织学特征作出判断。
急性乙型病毒性肝炎也很少做肝穿刺活检,其组织学改变与其他类型的病毒性肝炎大致相同,主要包括肝小叶排列紊乱、肝细胞嗜酸性变、局灶性肝小叶坏死、胆汁淤积、门管区炎症,严重的病例有桥接坏死。各文献中所报道的差别可能主要反映了选择患者的不同,而不是乙型病毒性肝炎的特征。然而,急性乙型病毒性肝炎常见淋巴细胞和巨噬细胞与肝细胞紧密接触,或甚至将肝细胞包入,这可能反映了细胞损伤的免疫特性。肝细胞的细胞核可有中度的多形性。在急性炎症的早期,仅检出很少量的乙型肝炎核心抗原和表面抗原(HBcAg和HBsAg),如有较多的阳性染色表明为慢性炎症。在移植后发生的HBV感染则例外,两种抗原都大量存在。急性肝炎中未见毛玻璃样肝细胞。在一些母婴传播的肝炎,包括乙型和丙型,在门管区可见双折光性针状物。按照病情的严重程度及肝细胞坏死的程度,可将急性乙型病毒性肝炎分为普通型乙型病毒性肝炎和重型乙型病毒性肝炎。
发生急性普通型乙型病毒性肝炎时,可见弥漫性肝细胞肿胀、胞质疏松、透亮,细胞体积增大,变圆,呈气球样变。电镜下可见粗面内质网囊状扩张,部分核蛋白体脱落,滑面内质网及线粒体也扩张。细胞质水分明显增加,细胞器漂浮于胞质中。肝细胞也可表现为嗜酸性变,胞质浓缩呈嗜酸性颗粒,可进一步形成伊红均匀深染的嗜酸性小体。电镜下可见肝细胞质脱水,胞质基质致密度增加,细胞缩小,核皱缩。进而细胞体积更小,细胞器不能辨认,胞核消失,形成嗜酸性小体。肝小叶内可见点状或灶性坏死,肝细胞核浓缩或溶解消失,坏死处网状纤维断裂或塌陷并见淋巴细胞浸润,这些改变以肝小叶中心、中央静脉周围(即肝腺泡Ⅲ区)多见。肝窦充血、水肿,门管区及肝窦内有淋巴细胞和单核细胞浸润。Kupffer细胞肥大、增生,吞噬功能增强。
肝细胞胞质内可见胆色素淤积,胆小管内可有胆栓形成。淤胆的程度和血清胆红素与胆汁酸浓度有关。淤胆是由于肝细胞受损,不能进行正常的胆色素代谢和排泄,以及胆小管上皮细胞肿胀或受肿胀肝细胞压迫而致阻塞。临床黄疸性肝炎淤胆明显;临床无黄疸性肝炎一般无胆色素沉积;而急性淤胆型肝炎,淤胆为主要病变,胆色素严重沉积。
肝细胞坏死并被清除后,邻近的肝细胞可分裂增生以修复。再生的肝细胞体积增大,核大深染,核仁明显,常为双核或多核,胞质染色可加深。
在急性乙型肝炎发作早期,即使患者血清HBsAg阳性,肝细胞内一般很难找到HBV,肝组织中只有少数散在的HBsAg和HBcAg阳性的肝细胞。
病毒性肝炎中,有1%~3%的患者可发展为重型肝炎。重型肝炎可由多种病毒引起,但一般认为乙肝病毒是重型肝炎的主要病原。我国的资料表明81.1%的重型肝炎由乙肝病毒引起。按重型肝炎的病程及病理形态的不同,重型肝炎又可分为急性重型乙型病毒性肝炎和亚急性重型乙型病毒性肝炎。
(1)急性重型乙型病毒性肝炎:
肉眼观,肝脏显著缩小,尤以左叶为甚,重量显著减轻至600~800g,肝脏质地非常柔软,包膜皱缩,边缘锐薄。肝脏切面呈斑驳状,黄褐色与红色相间,或以黄褐色为主。肝脏的肉眼改变常称急性红色肝萎缩或急性黄色肝萎缩。
组织学检查,病变主要见于中央区,随着病变的加重,病变可扩展到周边区,此时肝细胞弥漫性大块性或亚大块性坏死,仅在小叶周边残存少量的肝细胞,其间散布着较多的炎症细胞,包括巨噬细胞、淋巴细胞、单核细胞、少数中性粒细胞和嗜酸性粒细胞。嗜银纤维染色证明肝小叶网状支架尚存,此为急性黄色肝萎缩的特征。病变发展,变性坏死的肝细胞被吸收,肝窦扩张充血、出血,Kupffer细胞增生并吞噬被破坏物质、胆色素和脂褐素等,无肝细胞再生,呈急性红色肝萎缩图像。超过50%的病例肝组织内可见淤胆现象,网状支架不塌陷,或少量不完全塌陷,无Ⅰ型胶原形成,可见少量Ⅲ型胶原形成。连续切片免疫组化染色显示多数坏死区周围可出现胆管样或腺泡样肝细胞团,沿着无塌陷网架有序再生。病变极重者,几乎全部的肝细胞溶解而仅残存门管区胆管,患者很快进入深昏迷状态。由此可知肝实质的坏死量与患者的存活率有着密切的关系。坏死>2/3者,多不能存活;反之,肝细胞保留50%以上,肝细胞虽有变性和功能障碍,度过急性阶段,肝细胞再生迅速,可望恢复。如发生弥漫性小泡性脂肪变性,预后往往较差。
(2)亚急性重型乙型病毒性肝炎:
多数由急性重型肝炎发展而来,有些由急性普通型肝炎恶化所致。亚急性重型肝炎的组织学特征为肝细胞呈亚大块坏死、桥接坏死、多小叶坏死,且肝细胞再生十分明显。肝组织内出现大小不等、新旧不一的坏死灶,肝小叶结构完全被破坏。坏死灶内网状支架塌陷,门管区集中。肝细胞再生十分明显,因网状支架塌陷使再生肝细胞失去原有的依托,而呈不规则结节状,形似假小叶但非真性假小叶,其周围为塌陷网状支架而不是胶原纤维包绕。再生结节内肝细胞呈不同程度变性及胆汁淤积。有时在再生结节内出现新的坏死灶和新的肝细胞再生,形成了亚急性重型肝炎特有的新老病变交替的组织像。门管区旁及再生结节的附近见卵圆细胞、小肝细胞和小胆管增生。坏死灶及门管区可见淋巴细胞、大单核细胞、浆细胞、中性粒细胞及巨噬细胞浸润。Kupffer细胞增生、肥大,吞噬胆色素。由于较大范围肝细胞坏死,肝脏体积缩小,重量减轻。由于肝细胞再生明显,肝切面见岛状再生结节凸出,周围为柔软的土黄色松脆的坏死区。肝脏因胆汁淤积呈黄绿色。部分再生的肝细胞呈毛玻璃样,地衣红染色呈阳性反应。电镜观察可见该细胞的滑面内质网内有排列成线状的HBsAg。
通常,丙型病毒性肝炎的组织学特征与其他急性病毒性肝炎相同,其基本病变为肝细胞呈弥漫性变性、坏死、炎性渗出和肝细胞再生。但在急性丙型病毒性肝炎及由于丙型肝炎病毒引起的母婴传播的非甲非乙型肝炎,有两个可区别的特征。第一,有明显的肝窦炎症细胞浸润而没有严重的肝细胞损伤,看起来像传染性单核细胞增生症。第二,在慢性肝炎中所见的特征,如明显的淋巴滤泡形成和胆管损伤,也可见于急性丙型病毒性肝炎发病的几星期或几个月内。脂肪变性相当常见。也可有胆汁淤积,并出现类似原发性胆汁性胆管炎早期病变时的异常胆管上皮,这一特征被认为是丙肝慢性化的重要组织学指标。丙型肝炎病毒引起多肝腺泡坏死的急性重型肝炎非常少见。
在坏死区和门管区浸润的炎症细胞以CD3 + CD8 + 细胞为主,提示细胞毒性T细胞对肝细胞的免疫攻击;在恢复期CD3 + CD8 + 细胞明显减少。用免疫组织化学方法可检测组织切片中的HCV抗原,阳性物质呈均质颗粒状分布于肝细胞核内(核型)或胞质中(质型)。在胞质中呈弥漫分布者为均质型,聚集成块者为包涵体型。HCVAg阳性肝细胞呈单个散在型或片状分布,多位于肝小叶周边部,肝小叶中央较少。应用原位分子杂交技术可见肝细胞癌癌旁肝组织中阳性肝细胞内的HCV RNA阳性颗粒呈质型和核型,在质内可呈包涵体型。
丁型肝炎病毒是一种缺陷型RNA病毒,它可与乙型肝炎病毒合并感染引起丁型病毒性肝炎。乙型肝炎如合并或继发丁型肝炎病毒重复感染,可改变乙型肝炎的病程,使病程转慢性并加重。急性丁型病毒性肝炎组织学改变与乙型肝炎所见基本相同,但小叶内坏死及炎症较乙型肝炎显著。常见肝细胞嗜酸性变和微泡状脂肪变性,肝细胞嗜酸性变可伴有单个核细胞浸润。
有HBV感染标志的严重急性肝炎的患者,实际上可能是由于慢性HBV携带状态重复HDV感染。在美国印第安纳州的一次急性丁型病毒性肝炎流行中,显著的特征包括轻度的脂肪变性、淋巴细胞及大量的巨噬细胞浸润肝实质以及门管区。在流行的后期,有广泛的坏死和衰竭。有报道发现肝细胞发生微泡状脂肪变性和嗜酸性坏死。在非免疫抑制患者有HDV感染时,肝穿刺标本显示肝实质坏死和炎症。另一方面,在肝移植患者中有时发现有HDV感染而无HBV的感染,也无肝炎的改变。
丁型肝炎病毒抗原在石蜡切片中用免疫组化方法易于检出,主要见于肝细胞核,在核内可呈斑点状、带状或弥漫性分布,可有细小的颗粒状中心,称为沙粒核。有时也可见胞质和细胞膜染色。病毒RNA可在常规切片中用原位杂交检测。
在HBcAg和HDAg均阳性的肝组织标本中发现,HBcAg和HDAg多分别位于不同的肝细胞中,即使肝细胞内同时有HDAg和HBcAg,也分别位于肝细胞的不同部位。
这一型肝炎是由于消化道感染戊型肝炎RNA病毒引起,此病在亚洲引起流行,也见于非洲和北美洲。此型感染一般不转向慢性。组织学形态特点类似甲型病毒性肝炎,肝组织活检可见戊型肝炎急性期除具有急性病毒性肝炎的基本病变外,肝细胞水变性中往往夹杂有肝细胞羽毛状变性,易见较明显的胆小管内胆栓和肝细胞内淤胆,易见双核、多核肝细胞,小叶内坏死炎症常较轻微,多以小范围的点状或灶状坏死为主,易见肝细胞凋亡小体。肝窦旁细胞增生活跃,结合免疫组化检测,显示增生的窦细胞主要为Kupffer细胞,该细胞于炎症病变明显处增生尤为突出。门管区扩大,易见淋巴细胞、浆细胞浸润。免疫组化检测发现浸润的多为CD8 + 细胞,部分含HEV的肝细胞无变性改变,故认为HEV不直接损害肝细胞。电镜观察见肝细胞肿胀,内质网扩张,线粒体形态异常,糖原减少,HEV颗粒散在分布于胞质基质中。淋巴细胞常与这种肝细胞密切接触,表明本病肝细胞损害可能是由于细胞免疫反应引起。有报道在戊型病毒性肝炎死亡病例的肝中见轻微的门管区炎症、较多的胆汁淤积及严重的静脉炎。在增生的胆小管中电镜下可见病毒颗粒。
庚型肝炎病毒是近年发现的肝炎RNA病毒,它与同年由另一研究组发现的GB病毒-C是同一病毒的两个分离株。至于庚型肝炎病毒是否是引起肝炎损伤的真正肝炎病毒尚不明确,仍存在争议。因为庚型肝炎病毒大多数是在其他肝炎病毒引起的肝炎中检测出,或在无肝炎的供血者血中发现;仅有庚型肝炎病毒感染的通常无肝病。有研究发现,在急性甲型病毒性肝炎的肝中发现有庚型肝炎病毒,感染率约为25%。有合并庚型肝炎病毒感染的肝炎,门管区有较多的炎症细胞浸润。另有一些报道显示,在不明原因的急性重型肝炎中,应用RT-PCR检测庚型肝炎病毒RNA的NS3区,发现有庚型肝炎病毒感染。在急性重型肝炎肝衰竭的患者中,检测出在NS3区序列六个核苷酸突变的庚型肝炎病毒突变株,而在对照组及非急性重型肝炎肝衰竭中很少检及此突变株。上述研究提示,庚型肝炎病毒可能与急性及急性重型肝炎有关。但也有报道认为庚型肝炎病毒感染与肝中纤维化、门管区淋巴细胞浸润及临床进程无显著关系。
除了肝炎病毒引起的急性肝炎外,还有其他一些病毒也可引起肝炎。如巨细胞病毒、黄热病病毒、单纯疱疹病毒、风疹病毒、EB病毒等都可能引起急性病毒性肝炎,这些肝炎常表现为肝细胞坏死、变性及炎症细胞浸润,临床上出现黄疸,有的甚至出现肝衰竭。
有报道显示,在成年人巨细胞肝炎的肝细胞胞质内有副黏液病毒样结构。其他的一些患者,其病因可能是以上所列肝炎病毒之一种,或是一种自身免疫型的肝脏疾病。
EB病毒为非亲肝病毒、自限性疾病。病理变化为肝小叶炎轻微,肝细胞淤胆不常见,肝窦内单个核细胞呈串珠样排列,汇管区浸润的炎症细胞包括B淋巴细胞、T淋巴细胞和NK细胞,可见异型的淋巴母细胞、静脉内皮炎,可伴肝细胞脂肪变、肉芽肿和胆管系统损伤(图4-18-1)。EB病毒编码的小RNA(EBER)原位杂交证实病毒(图4-18-2)。

图4-18-1 EB病毒性肝炎

图4-18-2 肝组织EB病毒原位杂交染色
腺病毒肝炎常见于免疫缺陷的儿童或成人,如HIV患者,造血系统恶性肿瘤或移植后患者。病理改变主要表现为广泛的肝细胞坏死和轻微的炎症反应,肝细胞内易查见病毒包涵体(图4-18-3)。病毒包涵体位于肝细胞核内,圆形、嗜碱性、淡染。此型病毒常引起严重的肝炎,并导致肝衰竭,预后差。腺病毒免疫组化染色(图4-18-4)和外周血病毒DNA定量可证实病毒感染。
图4-18-3 腺病毒肝炎

图4-18-4 肝组织腺病毒免疫组化染色
近30年来,一直使用传统的慢性肝炎病理形态分类法,将慢性病毒性肝炎分为慢性持续性肝炎、慢性活动性肝炎、慢性小叶性肝炎等类型,这一分类法的主要依据是各型慢性肝炎预后的不同。虽然一些慢性持续性肝炎的患者可发展成慢性活动性肝炎,但大多数慢性持续性肝炎患者的预后要比慢性活动性肝炎的好。但目前已认识到,病毒性肝炎的预后和病程明显地受到引起损伤的病毒或其他病因的影响,受病毒复制程度的影响,还受机体对治疗反应的影响。而且,坏死的类型在评估疾病的进程中很重要,但没有在旧的分类中体现出。因为慢性肝炎的病因可能是临床实践中需考虑的最重要因素,所以现在越来越倾向于应用病原作为主要的分类法,再结合组织学的特征。现在比较少用传统病理学分类法的另一个原因是,病理医师在实践中发现在慢性持续性肝炎和轻微的慢性活动性肝炎之间难于作出确诊。此外,近年来越来越清楚地认识到慢性持续性肝炎、慢性活动性肝炎和慢性小叶性肝炎并不是独立的损伤,而是代表了连续病程的不同阶段。有关肝炎病毒的理论及血清学检查发展迅速,将越来越多地应用原位杂交来检测病毒DNA和RNA,因而结合病毒病因进行分类是具有实用意义的。
慢性病毒性肝炎的主要特征是持续的肝源性病毒感染超过6个月,常表现为慢性炎症、肝细胞损伤和进行性的纤维化。常见的病毒包括乙型、丙型和丁型肝炎病毒。慢性病毒性肝炎的临床症状常非特异,主要表现为乏力。患者可表现为右上腹轻度不适、关节疼痛、厌食。随着病变进展,可表现为肌肉萎缩、黄疸、水肿和精神萎靡。与慢性病毒性肝炎有关的特征性生化指标是转氨酶,转氨酶水平常介于正常值与正常值上限(ULN)的10倍之间,偶尔在患者病情活动时转氨酶可高于正常值上限的20倍。多数慢性病毒性肝炎患者的转氨酶水平常处于正常值范围。慢性病毒性肝炎进展的证据包括血浆白蛋白、国际标准化比值(INR)和胆红素水平升高。肝硬化可以通过出现门静脉高压的症状进行推测,如出现脾大,实验室检查发现血小板减少。天冬氨酸转氨酶(谷草转氨酶,aspartate aminotransferase,AST)与血小板的比值与肝硬化的出现有关。一旦患者被确诊为慢性病毒性肝炎,疾病的严重程度评估非常重要,肝穿刺活检是确保进行慢性肝炎分级、分期和启动抗病毒治疗的关键。
除了慢性小叶性肝炎外,多数慢性肝炎的患者都可表现为大部分的门管区有炎症细胞浸润。中度慢性肝炎,炎症细胞浸润完全局限在门管区,肝细胞界板保留完整。可伴有或不伴有肝细胞的损伤和炎症细胞浸润,相当于传统分类中的慢性持续性肝炎。用胶原纤维染色或网状纤维染色显示有完整的肝腺泡结构,门管区和中央静脉形态规则。门管区常由于炎症而扩大,并见少量纤维从门管区伸出。当出现门管区显著增大时,常提示先前有门管区旁的坏死(慢性活动性肝炎),随后肝界板重建。相反,局限于门管区的炎症,由于肝细胞坏死可向肝腺泡内发展。
浸润的炎症细胞主要是淋巴细胞,特别是在慢性丙型肝炎,淋巴细胞可聚集或形成淋巴滤泡,可有或无明显的生发中心。在门管区旁受浸润时,也可见到浆细胞。肝炎病原的不同,可有不同类型、不同数量的炎症细胞。小叶间胆管可出现灶性异常,如部分胆管上皮肿胀、上皮细胞空泡化和淋巴细胞浸润。
在慢性肝炎时,肝实质细胞也会发生改变,可发生坏死等损伤,主要表现为两个区域的改变。
在一些较严重的慢性肝炎,炎症细胞浸润可超出门管区,并有肝细胞坏死。这种坏死-炎症过程称碎屑状坏死,指慢性活动性肝炎的损伤。这种损伤的另一名称为交界性肝炎,因为它特征性地位于门管区和肝实质之间的交界区。这种肝炎的严重程度不同,最轻度的仅表现为受累的门管区扩大、肝界板稍不规则及存活的肝细胞被围绕在浸润的炎症细胞中。较严重的病例,在低倍镜下清晰可见炎症细胞浸润扩展入肝腺泡,并有明显的纤维化。
在肝腺泡的深部,上述改变也可伴有肝细胞灶性(点状)或融合坏死,还可见桥接坏死。在门管区炎症浸润但无门管区旁坏死的活检标本中,肝腺泡内坏死通常很轻;而桥接坏死常伴有碎屑状坏死。碎屑状坏死和桥接坏死在肝硬化发病中的相对重要性仍存在争议,两者可能都会影响预后。如同时出现碎屑状、灶状及有时伴有桥接坏死,为慢性肝炎临床病变进展的特征。如有脂肪变性,通常也很轻。少见胆汁淤积,如有胆汁淤积,需考虑其他诊断的可能性。
严重的肝腺泡内坏死,通常表现为桥接或全小叶坏死。在炎症坏死组织中常见有存活的肝细胞形成小腺样结构,这些称为肝细胞玫瑰花环的结构外包绕着结缔组织,玫瑰花环结构可能是由于再生形成的,一些细胞胞质内可见深伊红色颗粒,这些细胞的意义尚不明确。用乙型肝炎表面抗原染色可将这些细胞与乙型肝炎的毛玻璃样细胞区别。
极少一部分严重慢性肝炎的患者,一些肝细胞融合形成多核巨细胞。巨细胞性肝炎似乎并不是由于单一病因引起,已有报道副黏液病毒也可引起此型肝炎。
偶有报道发现肝腺泡坏死及炎症细胞浸润,但无门管区或门管区旁的改变。这种组织特征与慢性小叶性肝炎相似,如果病变轻微,称为非特异性或轻微肝炎。
慢性持续性肝炎(chronic persistent hepatitis,CPH)临床症状及肝功能损害均较轻,预后较好。乙型肝炎病毒是最重要的病因,丙型肝炎病毒次之,甲型肝炎病毒一般不引起慢性肝炎。
慢性持续性肝炎的病理变化主要表现为门管区炎症,门管区有淋巴细胞、单核细胞和巨噬细胞浸润,门管区可扩大,但边界清楚。肝细胞变性坏死均不明显,肝细胞气球样变和嗜酸性小体少见,偶见少数灶性坏死,但一般无碎屑状坏死。肝小叶结构无明显紊乱。Kupffer细胞轻度肥大。肝小叶内有时有灶性或呈带状的炎症细胞浸润。偶见结缔组织增生或纤维隔形成,自门管区向肝小叶内伸展。肝脏轻度肿大,色暗红或苍白,表面光滑而略粗糙,但无结节,可见扩张的血管。肝包膜常有渗出的白色纤维素沉着,形成条纹样结构。
乙型肝炎病毒引起者,可见有毛玻璃样肝细胞,地衣红染色阳性,免疫组化染色HBsAg阳性。免疫电镜检查,见肝细胞胞质内或细胞膜含有HBsAg颗粒。
慢性活动性肝炎(chronic active hepatitis,CAH)是指肝脏的炎症持续6个月以上,并有可能发展成肝硬化等严重的肝病。慢性活动性肝炎可由肝炎病毒引起,如HBV、HBV合并HDV、HCV等。也可由其他非病毒病因引起,如自身免疫、某些药物、酒精中毒等。
慢性活动性肝炎的病理特征主要表现为肝细胞碎屑状坏死及炎症细胞浸润。肝细胞气球样变和嗜酸性小体较多见,肝小叶结构紊乱,小叶内灶状坏死、碎屑状坏死较多,甚至可出现桥接坏死。炎症细胞浸润门管区、小叶内和小叶间隔,包括淋巴细胞、单核细胞、浆细胞和巨噬细胞等。肝界板由于炎症受到破坏,门管区扩大,边缘不整,呈锯齿状。门管区及小叶间有纤维组织和小胆管增生,并有小肝细胞和再生的肝细胞。早期肝略肿大,色暗红或褐色,表面有轻度凹凸不平的粗糙感。后期肝表面有结节形成。
慢性活动性肝炎免疫组化染色,大多数呈HBsAg阳性。部分病例HCV或HDV Ag呈阳性。
慢性小叶性肝炎(chronic lobular hepatitis,CLH)是指病程超过6个月而肝小叶内仍有坏死和炎症者。1977年国际会议提出设立此型,但我国1990年肝炎病理诊断标准中,将其归入慢性迁延性肝炎的一个亚型。慢性小叶性肝炎的病因主要为HBV,其次为HCV,另有少数病例与药物或化学毒物有关。
慢性小叶性肝炎病理组织学的主要特征是肝小叶内有不同程度的肝细胞变性、坏死和炎症反应,而门管区的炎症反应不明显。肝细胞呈气球样变和嗜酸性变,肝窦明显狭窄。肝细胞灶性坏死,有淋巴细胞和单核细胞浸润,Kupffer细胞增生,轻度胆汁淤积。
慢性小叶性肝炎HBsAg免疫组化染色的阳性率,报道各不相同,从67.5%~100%,主要表现为胞质内包涵体型。
慢性重型肝炎(chronic fulminant hepatitis,CFH),是在高度活动性的肝硬化或重度慢性活动性肝炎等慢性肝病的基础上发生的,临床表现与亚急性重型肝炎相似,但有慢性活动性肝炎或肝硬化的病史、体征及严重的肝功能损害。慢性重型肝炎的病理改变较复杂,既有肝硬化假小叶形成的特征,又有亚急性重型肝炎坏死严重的特征。肝组织中可见亚大块坏死、桥接坏死及碎状坏死。并见胆管增生、胆栓形成及炎症细胞浸润。慢性重型肝炎与亚急性重型肝炎的主要区别在于:慢性重型肝炎有真正的假小叶形成;而亚急性重型肝炎虽有肝细胞再生结节,但不是真正的假小叶。
1994年6月在墨西哥召开的世界肝病学会学术会议上,推荐以病原作为划分慢性肝炎分类的首要标准,而废弃慢性持续性肝炎、慢性活动性肝炎、慢性小叶性肝炎及慢性重型肝炎等诊断名词。
慢性乙型病毒性肝炎在我国较常见,而且一部分患者可发展成肝硬化,甚至可发生肝细胞癌。慢性乙型病毒性肝炎的组织学形态,在不同的患者或同一患者疾病的不同阶段有很大的差异。肝活检在判断肝炎的严重程度、判断预后及观察慢性乙型肝炎患者的疗效方面很有价值。慢性乙型病毒性肝炎最常见的特征是门管区炎症和门管区旁坏死。可见门管区旁较严重的坏死,引起界板的破坏。随着肝炎的发展,可发生纤维化,甚至肝硬化。慢性病变常始于病毒复制的高峰期,特征为肝细胞中有大量的HBV DNA,血清中有HBeAg。在此阶段,组织损伤可较严重,活检中可见门管区旁和肝腺泡内肝细胞坏死。典型的毛玻璃样细胞单独散在分布于整个肝腺泡中,免疫组化可证实在毛玻璃样细胞中有大量HBsAg的存在,HBsAg大多见于肝细胞的胞质内(图4-18-5),HBsAg免疫组化染色颗粒可散布在胞质中(全质型)、胞膜下(膜型)或浓集在一起(包涵体型)。HBcAg可见于肝细胞核中,当病毒复制活性高时,也可见于胞质中。肝细胞核中含有大量的核心物质,使核呈淡嗜酸性,又称为沙粒核。相似的形态也可见于有大量的HDV时。有报道肝细胞核和细胞质含有大量的HBcAg时,用亲苯胺蓝可染成红紫色。除了HBsAg和HBcAg外,HBeAg也可用免疫组化的方法检测出。

图4-18-5 肝组织HBsAg免疫组化染色
大量病毒复制阶段,血清中有大量HBeAg。随后进入低复制阶段,血清中无HBeAg而出现抗-HBe抗体。在低HBV复制期,组织学改变较轻微,炎症反应较轻,局限于门管区。此时常见大量的毛玻璃样细胞,通常无HBcAg。最后HBsAg可从血清中消失,感染的征象仅是存在抗体。在HBsAg消失后一段时间,可能仍见轻度的炎症。但此时病理医师应注意有无其他病毒重复感染的组织学特征。作为先前坏死及继发改变的结果,肝组织可有严重的纤维化甚至肝硬化。
在感染了突变株病毒的患者,e抗原的表达缺陷,即使没有HBeAg的存在而有抗-HBe的存在,组织学的改变仍很明显。在免疫抑制的患者,虽然没有显著的组织学改变,但可发现大量的HBcAg。病毒高复制和低复制阶段在临床上可由周期性的病情加重及缓解来区分。在所有的活动性HBV感染的标志消失后,患者的肝细胞核内仍含有整合型的HBV DNA。
除了存在有毛玻璃样肝细胞和HBV抗原,慢性HBV感染的特征通常是肝细胞核的大小和外观改变,肝细胞和淋巴细胞更紧密接触。这些淋巴细胞常是CD8 + 型,而门管区浸润的为大量的CD4 + 型淋巴细胞、B淋巴细胞和巨噬细胞。在坏死区存在的CD8 + 淋巴细胞,与肝细胞表达的细胞间黏附分子1(ICAM-1)有关,与病毒的复制无关。
慢性乙型肝炎的组织学分类传统上分为慢性持续性肝炎、慢性活动性肝炎、慢性小叶性肝炎和肝硬化。组织学分为慢性持续性肝炎和慢性活动性肝炎,先前是用来区别预后的不同,但最近的研究发现患者可从慢性持续性肝炎发展成慢性活动性肝炎,提示这两种肝损伤可见于同一慢性乙肝患者的不同阶段。
近年来,已有几个量化系统用来更客观地表达肝损伤,并可进行统计比较坏死、炎症和纤维化。最著名的系统是Knodell组织活性指数,引入了四个指数:门管区旁和桥接坏死,肝小叶内变性和灶性坏死,门管区炎症,以及纤维化。近年有国际统一方案提出慢性肝炎患者的病理组织报告应包括慢性肝炎的病因、坏死炎症的程度以及纤维化的程度。
在输血后发生的丙型病毒性肝炎,常表现为慢性病程,很多患者可发展成肝硬化,而且常在许多年后或甚至数十年后,最后伴发肝细胞癌。此型慢性肝炎发病时常较轻,仅表现为轻度或无门管区旁病变,组织学变化介于慢性持续性肝炎和慢性活动性肝炎之间。在进展期,则有轻度门管区旁和肝腺泡内碎屑状坏死并伴有炎症,桥接坏死较少见。在疾病的晚期可见门管区内纤维化、门管区之间纤维化或门管区-中央静脉间纤维化,偶尔可见肉芽肿形成。肝脏大小正常或稍增大,边缘钝,质较硬,包膜增厚,呈暗红色。肝活检可决定炎症的程度(分级)和纤维化的程度(分期),以及是否存在肝硬化。
慢性丙型病毒性肝炎的组织学改变具有其特征性,主要表现为:门管区淋巴滤泡形成、小叶间胆管损伤和肝腺泡损伤。门管区有大量淋巴细胞浸润,常聚集成堆或形成淋巴滤泡,有些合并有明显的生发中心。这些生发中心含有活化的B细胞,周围有滤泡树突状细胞和B细胞外套区。在外围T细胞区,主要为CD4 + 细胞。淋巴滤泡不仅只见于丙型病毒性肝炎,也可见于乙型病毒性肝炎、自身免疫性肝炎和原发性硬化性胆管炎。然而,在丙型病毒性肝炎,淋巴滤泡特别常见且明显。在淋巴细胞浸润区内或其一侧,可见损伤的小叶间胆管。胆管损伤的改变包括上皮细胞空泡化、上皮细胞复层化及聚集一起的淋巴细胞浸润等。肝腺泡损伤包括肝细胞嗜酸变性、凋亡形成、大泡性脂肪变性及肝窦中见淋巴细胞。大泡性脂肪变性比其他类型的病毒性肝炎更常见,但由于产生脂肪变性的原因是复杂的,所以这种表现无诊断价值。有学者报道在门管区旁的肝细胞内有集聚的物质似Mallory小体。窦周隙有局灶性或弥漫性淋巴细胞浸润,弥漫性浸润呈现串珠样外观。
国外有关丙型病毒性肝炎的病理组织学分类主要有三种,但这些分类法并不能区分临床上的急性或慢性肝炎,只是根据肝炎组织中以哪一种细胞改变为主而命名。这三种分类法为:①Scheuer分类法(嗜酸性变细胞型、淋巴细胞样型);②Bianchi分类法(嗜酸小体型、透亮细胞型、单核细胞增多症样型、成人巨细胞性肝炎);③尾关恒雄分类法(嗜酸性细胞型、淋巴细胞为主型、库普弗细胞为主型、透亮细胞型、成人巨细胞型)。单核细胞增多症样型多见于急性丙型病毒性肝炎,而嗜酸性细胞型多见于慢性丙型病毒性肝炎。但有学者认为这些分类临床意义不大。
应用原位杂交可在冷冻切片中检测出病毒RNA。也有应用免疫组化方法检测病毒抗原,阳性物质呈颗粒状分布于肝细胞核内或胞质中(图4-18-6),HCVAg阳性肝细胞呈单个散在或片状分布。

图4-18-6 肝组织HCVAg免疫组化染色
慢性丁型病毒性肝炎常继发于乙型病毒性肝炎,病程转慢性并加重。慢性丁型病毒性肝炎组织学改变与慢性乙型肝炎基本相同,但坏死及炎症较乙型肝炎显著。病变不仅局限于门管区,可能在门管区旁和肝腺泡的深部都可见坏死和严重的炎症反应。
肝组织的免疫组化染色可检测出HDV抗原,肝细胞内检测出HDAg被认为是诊断HDV的主要标准,HDAg阳性染色代表了有活动性感染。由于HDV依赖于HBV,所以HDV感染时一般均有HBsAg的存在。目前临床要确定是否有HDV感染,主要依赖于检测血清中抗-HDV。肝细胞中HDV RNA可用原位杂交检测出。
如前所述,庚型肝炎病毒大多数是在其他肝炎病毒引起的肝炎中检测出,主要在慢性丙型病毒性肝炎及慢性乙型病毒性肝炎中发现。庚型肝炎病毒的感染多在慢性肝炎中发现,临床症状较轻,病情易反复,易慢性化。单纯庚型肝炎病毒感染的肝脏,病理改变较轻,主要表现为慢性迁延性肝炎的病理组织征象。实验发现,恒河猴感染庚型肝炎病毒后,第2个月肝组织出现点状、灶性及轻度碎屑性坏死,并持续受损,庚型肝炎病毒感染后18个月,肝脏呈慢性病毒性肝炎改变。合并HGV及其他类型病毒感染的慢性肝炎,则主要表现为其他类型病毒性肝炎的病理组织征象。似乎庚型肝炎病毒合并感染并不加重乙型及丙型肝炎的肝脏损害,也不影响HBV、HCV的复制和病毒血症水平。合并持续性HGV感染是较常见的,但这一感染并不改变乙型及丙型肝炎患者的临床进程。庚型肝炎病毒的感染也不导致肝硬化的发生。
应用免疫组化方法检测HGV NS5区抗原,发现阳性染色大部分定位于肝细胞胞质中,部分有核着色和膜染色,阳性细胞数量少,大多散在分布,部分呈灶性分布。阳性细胞周围可见较多淋巴细胞浸润,提示免疫损伤可能参与了庚型病毒性肝炎的肝脏损伤机制。应用RT-PCR方法可在患者血清中检测出HGV RNA。
由于应用现有的诊断方法并不能证实所有的慢性病毒性肝炎都是由HBV、HCV及HDV引起的,因而推测存在慢性非A、非B、非C和非D肝炎。在一些慢性肝病活检中见副黏液病毒样结构,或表现为巨细胞性肝炎,提示还存在其他类型的慢性病毒性肝炎。
根据流行病学调查发现,在我国及东南亚一带有广泛的HBV隐性感染,HCV感染也有类似情况。据估计在我国至少有三分之一的成年人曾经有过急性无症状HBV感染而获得免疫。HBV和HCV的感染常呈现为隐匿的过程,大多数HBV和HCV感染可无症状。但肝脏组织中可存在轻微的病变,并可发展为进展性损害。临床可出现间歇性疲乏感或其他非肝病所特有的症状。
HBV无症状携带者的肝活检发现,大部分携带者肝组织有不同程度的炎症改变,主要在肝小叶内,门管区则较轻,肝组织内见散在的毛玻璃样肝细胞。电镜下见毛玻璃样肝细胞滑面内质网增生并呈小泡状弥漫分布,滑面内质网内可见电子密度较高的丝状和颗粒状物质,直径19~25nm。这些丝状和颗粒状物质是HBV在胞质内存在的形式。胞质内并见糖原颗粒明显增多,呈不规则致密颗粒状。粗面内质网可正常或减少,也可呈轻中度扩张。线粒体减少、肿胀,基质密度降低,线粒体嵴减少或消失。Kupffer细胞及内皮细胞可发生增生。少数携带者肝组织可正常。
HBV携带者的诊断主要有3个指标:①血清携带HBsAg持续半年以上;②肝功能基本正常,无临床症状和体征;③少数携带者肝组织正常,多数有轻微的炎症或非特异性变化。肝穿刺组织HE染色可见毛玻璃样肝细胞,地衣红染色阳性,免疫组化染色HBsAg阳性。
近年来,虽然随着肝脏影像学技术的快速发展,肝脏形态学检查方法如B超、CT、磁共振等已应用于临床,但肝脏组织病理学检查仍然是迄今诊断肝脏疾病、评价肝损害程度的“金标准”,其结果直接影响到对患者病情的评估、预后的判断和不同的临床处置策略。尤其在一些诊断上可能发生混淆的情况下,如自身免疫性肝炎、原发性胆汁性胆管炎等的诊断,或为了明确某些原因不明的肝功能异常的病因时,肝穿刺活组织检查具有不可替代的作用。在慢性病毒性肝炎患者,通过肝组织学检查明确肝脏炎性反应及纤维化程度,更有效客观地评估疾病所处的阶段,并可将其作为合理选择抗病毒药物治疗的指征,其作用愈加受到关注。
1994年世界肝病学会学术会议提出了关于慢性肝炎诊断、分级、分期的诊断方案,该方案提出对慢性肝炎的最后诊断必须包括3个内容:病原、分级和分期。该方案建议按照感染的病原或其他发病病因,将慢性肝炎分为:①慢性乙型肝炎;②慢性丙型肝炎;③慢性丁型肝炎;④慢性病毒性肝炎(由未定或未知病毒引起);⑤自身免疫性肝炎;⑥慢性肝炎(无法确定病因);⑦慢性药物性肝炎。
上述慢性肝炎的分类及其分级和分期标准,于1996年在武汉市召开的全国病毒性肝炎会议上被认可,并开始推广使用。
2000年9月在西安由中华医学会传染病与寄生虫病学会、肝病学分会联合举办的第十届全国病毒性肝炎大会通过了“病毒性肝炎防治方案”中的组织学标准。会议认为病理组织学检查在肝脏疾病的诊断、分类及预后判定上具有重要作用,是衡量炎症活动度、纤维化程度以及判定药物疗效的重要标准。随着国内外肝穿刺活检开展日益广泛,为正确诊断,肝穿刺标本长度须在1cm以上(1.5~2.5cm),至少包括3个以上门管区。肝穿刺标本应作连续切片,常规行HE染色及网状纤维和/或Masson三色染色,以准确判断肝内炎症、结构改变及纤维化程度,并进行肝组织内病毒抗原或核酸原位检查,以帮助确定病原及病毒复制状态。
会议提出病毒性肝炎病理组织学诊断依病程分为急性与慢性病毒性肝炎。
急性病毒性肝炎为全小叶性病变,主要表现为肝细胞肿胀、水样变性及气球样变,夹杂以嗜酸性变、凋亡小体形成及散在的点状、灶性坏死,同时健存肝细胞呈现再生,胞核增大,双核增多或出现多核;Kupffer细胞增生,窦内淋巴细胞、单核细胞增多;门管区呈轻至中度炎症反应;肝内无明显纤维化。有的肝内可见淤胆,胆小管内形成胆栓,坏死灶及肝窦内有吞噬细胞聚集并吞噬黄褐色色素,临床具有黄疸者,较为明显。
各型急性病毒性肝炎基本病变相似,诊断时需要结合临床及血清病毒学检测进行分类。但不同类型肝炎病毒引起的病变形式及程度具有一些相对特点,在鉴别诊断中有一定参考价值。
急性甲型肝炎病变多较轻,特点有二:一是门管区炎症,较多淋巴细胞及浆细胞浸润,常波及门管区周围引起小叶周边炎症;二是中央静脉周围淤胆,而肝细胞损伤及炎症相对较轻。少数急性甲型肝炎可发生多腺泡坏死或大片坏死,但不演变成慢性。
急性乙型肝炎病理改变比较多样,肝细胞弥漫肿胀,气球样变及不同程度肝细胞坏死,门管区炎症较轻。急性乙型肝炎毛玻璃样细胞少见,如有大量HBsAg阳性反应则提示为慢性病变。
急性丙型肝炎小叶内可见灶状大泡脂肪变性,可见嗜酸性小体,肝窦内单个核细胞常排列成串;门管区炎症较重,小胆管损伤、周围淋巴细胞聚集或淋巴滤泡形成较其他型为多见。
较少见,绝大多数与乙肝相伴,小叶内炎症、坏死往往较重。
肝细胞肿胀、凋亡、坏死、淤胆常较明显,Kupffer细胞活跃增生吞噬脂褐素,门管区炎症水肿,常伴门管区周围炎症。
急性病毒性肝炎经过早期阶段,病变发展阶段,之后逐渐消退,残留改变可持续数月,最终多恢复正常。恢复的速度因患者而异,一般黄疸发病后数周作肝穿刺,可接近于正常,难作出急性病毒性肝炎的诊断。但可根据残留的组织学改变,如轻度门管区炎症;在腺泡及门管区见到吞噬色素的巨噬细胞簇集;肝细胞核的大小不一;以及肝窦网状纤维塌陷密集等,提示近期有肝细胞坏死,结合临床可确诊为急性肝炎恢复期。
急性病毒性肝炎有的病变较重,出现桥接坏死,但多可恢复,很少转为慢性。
慢性肝炎多非全小叶性病变,小叶内除有不同程度的肝细胞变性、坏死外,门管区及门管区周围炎症常较明显,常伴不同程度的纤维化,主要病变为炎症坏死及纤维化。
(1)炎症坏死:
常见有点状坏死、灶性坏死、融合坏死、碎屑性坏死及桥接坏死,后二者与预后关系密切,是判断炎症活动度的重要形态学指标。
1)碎屑性坏死(PN):
又称界面性肝炎(interface hepatitis),系肝实质与门管区或间隔交界带的炎症坏死,特点为炎症细胞浸润,主要为淋巴细胞或伴浆细胞,肝细胞坏死,肝贮脂细胞增生,致局部胶原沉积、纤维化。依病变程度分为轻、中、重度,是断定小叶炎症活动度的重要指标之一。①轻度:发生于部分门管区,界板破坏范围小,界面性肝炎局限;②中度:大部分门管区受累,界板破坏可达50%,界面性肝炎明显;③重度:炎症致门管区扩大,碎屑性坏死广泛,炎症坏死深达小叶中带,致小叶边界严重参差不齐,可致门管区周围有较广泛的胶原纤维沉积。
2)桥接坏死(BN):
为较广泛的融合性坏死,根据坏死连接部位不同可分为3类:①门管区-门管区(P-P)桥接坏死,主要由门管区炎症及碎屑性坏死发展形成;②门管区-小叶中央区(P-C)桥接坏死,沿肝腺泡Ⅲ区小叶中央与门管区炎症、坏死互相融合,常致小叶结构破坏;③中央-中央(C-C)桥接坏死,两个小叶中心带的坏死相融合。桥接坏死常导致桥接纤维化,与预后密切相关。桥接坏死的多少是决定中、重度慢性肝炎的重要依据之一。
(2)纤维化:
肝纤维化系指肝内有过多胶原纤维沉积,依其对肝结构破坏范围、程度和对肝微循环影响的大小划分为1~4期(S1~S4)。
S1:包括门管区和门管区旁纤维化及局限性窦周纤维化或小叶内纤维瘢痕形成。前者是门管区内炎症及门管区旁界面肝炎的后果,局限性纤维沉积致门管区扩大,或少量纤维组织伸入邻近肝实质中,形成门管区旁纤维化。局限性窦周纤维化及小叶内炎症可导致局限性纤维化,二者均不影响小叶结构的完整性。
S2:纤维间隔即桥接纤维化(bridging fibrosis)主要由桥接坏死发展而来,亦具有P-P、P-C、C-C三种形式,S2虽有纤维间隔形成,但小叶结构大部分仍保留。
S3:大量纤维间隔,分隔并破坏肝小叶,致小叶结构紊乱,但尚无肝硬化。此期一部分患者可出现门静脉高压、食管静脉曲张。
S4:早期肝硬化,肝实质广泛破坏,弥漫性纤维增生,被分隔的肝细胞团呈不同程度的再生及假小叶形成。此期炎症多尚在进行,纤维间隔宽大、疏松,改建尚不充分。与肯定的肝硬化的鉴别要点是后者纤维间隔包绕于假小叶周围,间隔内胶原及弹力纤维经改建而环绕假小叶呈平行排列。
将炎症活动度及纤维化程度分别分为1~4级(G)和1~4期(S),前者又将门管区及门管区周围炎症与小叶内炎症分成两项,分别按程度定级,当两项的程度不一致时,总的炎症活动度(G)以高者为准。慢性肝炎的分级、分期标准见表4-18-1。
将慢性肝炎按炎症活动度(G)划分为轻、中、重三度,如S>G,则应予特殊标明。
(1)轻度慢性肝炎(包括原来的慢性迁延性肝炎及轻型慢性活动性肝炎):
G1~2,S0~2。①肝细胞变性,点状、灶性坏死或凋亡小体;②门管区扩大,有或无炎症细胞浸润,见或不见局限性碎屑状坏死(界面肝炎);③小叶结构完整。
表4-18-1 慢性肝炎分级、分期标准

(2)中度慢性肝炎(相当于原来的中型慢性活动性肝炎):
G3,S1~3。①门管区炎症明显,伴中度碎屑状坏死;②小叶内炎症重,融合坏死或伴少数桥接坏死;③纤维间隔形成,小叶结构大部分保存。
(3)重度慢性肝炎(相当于原来的重型慢性活动性肝炎):
G4,S2~4。①门管区炎症重或伴有重度碎屑状坏死;②桥接坏死累及多数肝小叶;③多数纤维间隔形成,致小叶结构紊乱,或形成早期肝硬化。
(4)慢性肝炎的病理诊断:
肝炎活检标本病理诊断报告的内容应至少包括以下4个方面的信息。①明确作出慢性肝炎的诊断;②病变的程度;③病变分级分期(G、S)的结果;④慢性肝炎明确或怀疑的病因(按照临床血清学或组织内检测结果明确病因)。如当活检标本中出现毛玻璃样肝细胞或免疫染色乙型肝炎表面抗原和核心抗原阳性时则可以明确诊断为慢性乙型肝炎。
慢性肝炎病理报告格式举例:中度慢性乙型病毒性肝炎,G3/S2;重度慢性病毒性肝炎,乙型+丙型,G4/S3。
对于慢性肝炎的分级和分期的标准,国内外尚未统一。目前有多种定量的分级和分期系统,包括1981年的Knodell评分系统、1991年的Scheuer评分系统、1995年的Batts-Ludwig评分系统、1995年的Ishak评分系统、1996年的Metavir评分系统,一些评分系统比较复杂,目前国际常用的慢性肝炎的评分系统见表4-18-2~表4-18-6。
表4-18-2 Knodell慢性肝炎组织学活动指数(HAI)评分系统

续表

表4-18-3 改良简化的Scheuer组织学评分系统

表4-18-4 Ishak评分系统

续表

表4-18-5 Metarvir评分系统——组织学炎症活动度评分

* 组织学活动度A根据界面炎和小叶内炎症坏死程度综合确定。
表4-18-6 Metarvir评分系统——纤维化分期评分

重型肝炎的病变基础为肝细胞的急性广泛性坏死(大块、亚大块坏死或桥接坏死)伴或不伴重度肝细胞变性。坏死以Ⅲ区为重,向小叶周边发展,实质的坏死范围与存活肝细胞的比例是决定预后的重要因素。
肝细胞呈一次性大块坏死(坏死面积≥肝实质的2/3)或亚大块坏死,或桥接坏死,或坏死伴肝细胞的重度变性;坏死>2/3者,多不能存活;反之,50%以上的肝细胞存活,肝细胞虽有重度变性及功能障碍,度过急性阶段后,变性可望迅速恢复。如发生弥漫性小泡性脂肪变性,预后常较差。
病理形态学改变与发病阶段密切相关(根据临床经过,将起病10天后出现重型肝炎症候者,划归亚急性重型肝炎,与此相对应,亚急性重型肝炎的病理分成早、中、晚期变化)。发病早期可呈新鲜亚大块坏死或见大块坏死,病变比较单一,为一次性打击,犹如急性重型肝炎的改变,或有轻度门管区周围小胆管样增生,此阶段的预后与坏死范围密切相关。中期或进展阶段呈现新、旧(坏死区网状纤维塌陷,并有胶原纤维沉积)不等的亚大块坏死(坏死面积≤50%);小叶周边出现团块状肝细胞再生;小胆管增生,管腔内可有淤胆;常有明显的门管区及中央静脉炎症。晚期肝结节状再生更加明显,胶原沉积亦更加显著,有的可见宽阔纤维间隔分隔再生肝结节。
病变特点表现为在慢性肝病(慢性肝炎或肝硬化)的病变背景上,出现大块(全小叶性)或亚大块新鲜的肝实质坏死。
肝硬化伴明显炎症,包括间隔内炎症,假小叶周围碎屑状坏死及再生结节内炎症病变。
假小叶周围边界清楚,间隔内炎症细胞少,结节内炎症轻。
(陈丽红)